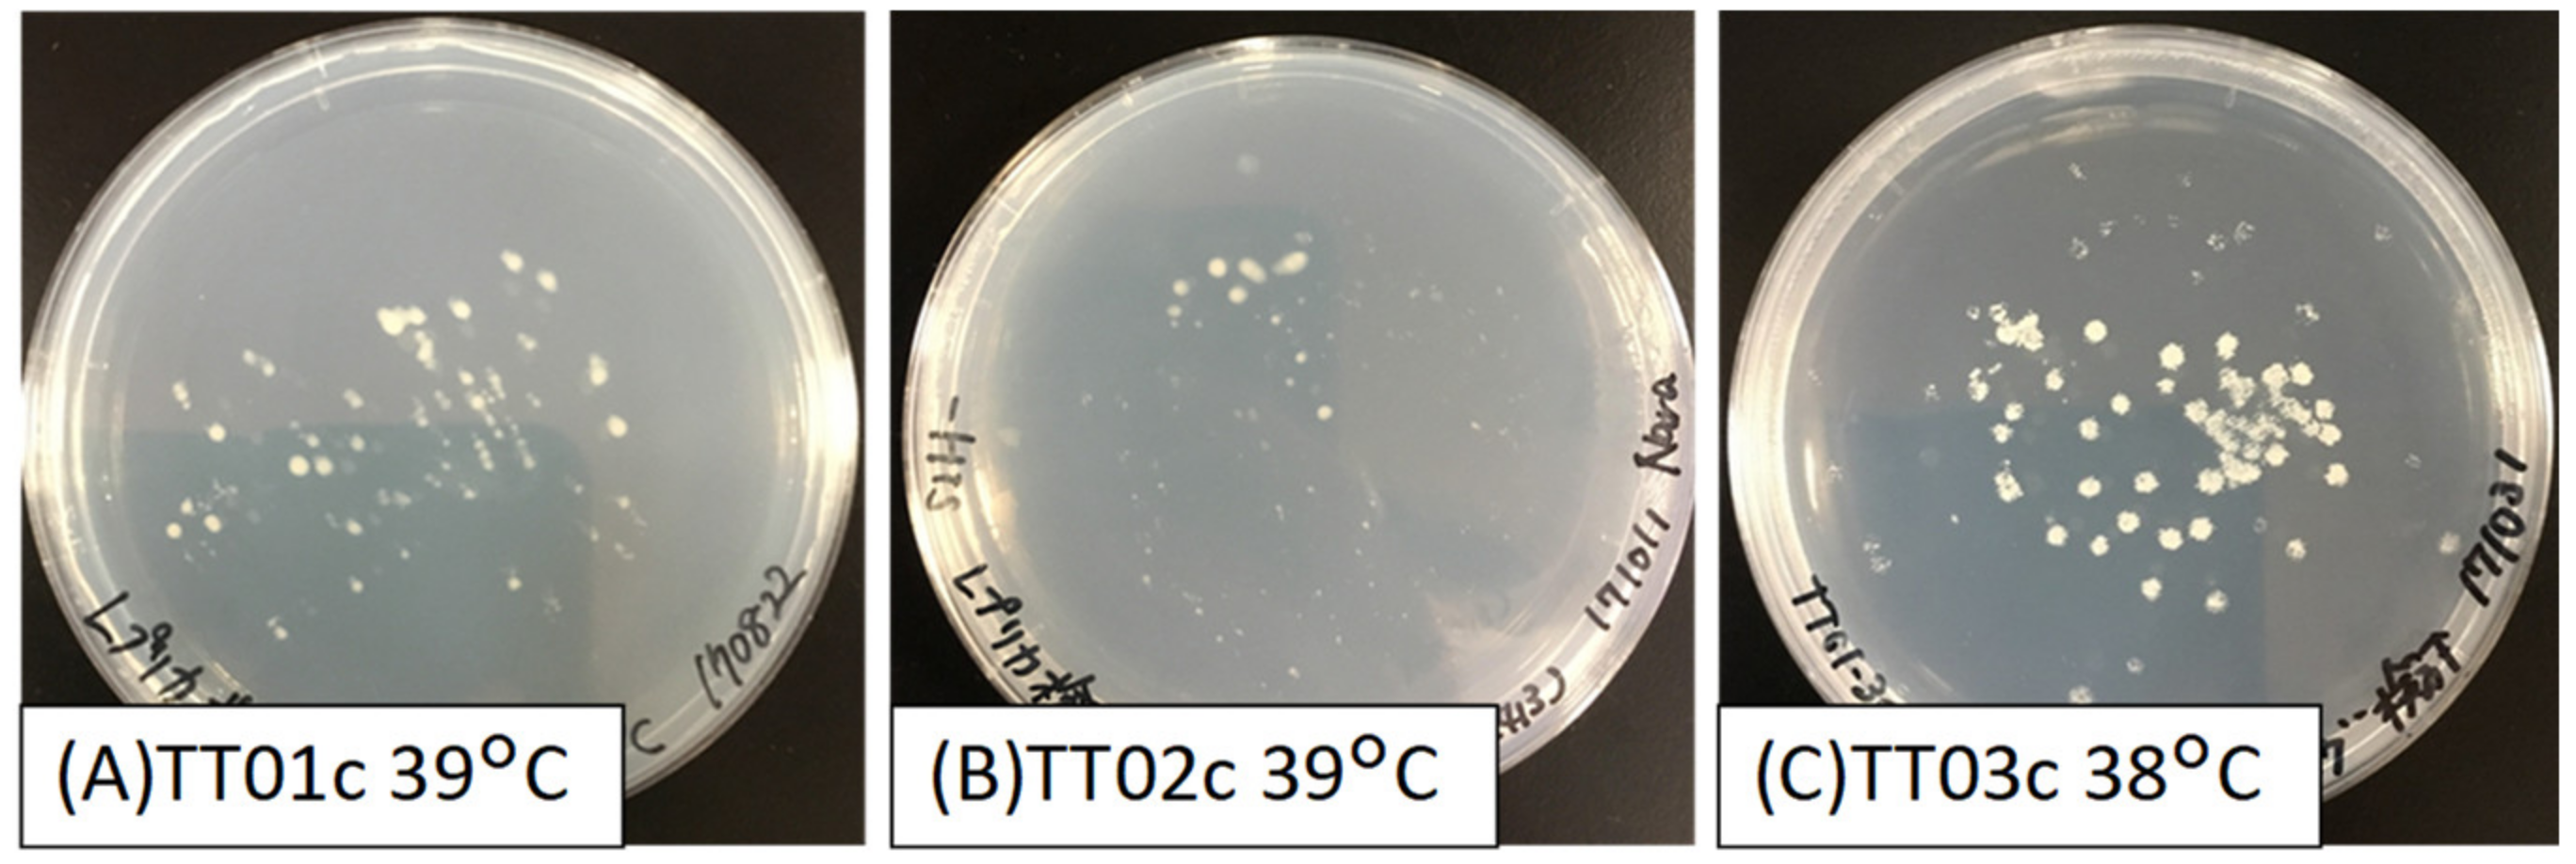

Random Transfer of Ogataea polymorpha Genes into Saccharomyces cerevisiae Reveals a Complex Background of Heat Tolerance
Abstract
1. Introduction
2. Materials and Methods
2.1. Strains, Plasmids, and Yeast Transformation
2.2. Culture Conditions
2.3. Construction of Screening System for the Heat-Resistant Evolved Strain
2.4. Confirmation of Reproducibility by Spot Method
3. Results
3.1. Comparison of Vectors for Artificial Random Gene Transfer
3.2. Screening of Heat-Tolerant S. cerevisiae Strains Expressing O. polymorpha cDNA
3.3. Reconstruction of Heat-Tolerant S. cerevisiae Strains
4. Discussion
Supplementary Materials
Author Contributions
Funding
Institutional Review Board Statement
Informed Consent Statement
Acknowledgments
Conflicts of Interest
References
- Soucy, S.M.; Huang, J.; Gogarten, J.P. Horizontal gene transfer: Building the web of life. Nat. Rev. Genet. 2015, 16, 472–482. [Google Scholar] [CrossRef] [PubMed]
- Yoshida, S.; Maruyama, S.; Nozaki, H.; Shirasu, K. Horizontal gene transfer by the parasitic plant Striga hermonthica. Science 2010, 328, 1128. [Google Scholar] [CrossRef] [PubMed]
- Zhang, D.; Qi, J.; Yue, J.; Huang, J.; Sun, T.; Li, S.; Wen, J.F.; Hettenhausen, C.; Wu, J.; Wang, L.; et al. Root parasitic plant Orobanche aegyptiaca and shoot parasitic plant Cuscuta australis obtained Brassicaceae-specific strictosidine synthase-like genes by horizontal gene transfer. BMC Plant Biol. 2014, 14, 19. [Google Scholar] [CrossRef] [PubMed]
- Novo, M.; Bigey, F.; Beyne, E.; Galeote, V.; Gavory, F.; Mallet, S.; Cambon, B.; Legras, J.L.; Wincker, P.; Casaregola, S.; et al. Eukaryote-to-eukaryote gene transfer events revealed by the genome sequence of the wine yeast Saccharomyces cerevisiae EC1118. Proc. Natl. Acad. Sci. USA 2009, 106, 16333–16338. [Google Scholar] [CrossRef] [PubMed]
- Hall, C.; Brachat, S.; Dietrich, F.S. Contribution of horizontal gene transfer to the evolution of Saccharomyces cerevisiae. Eukaryot. Cell 2005, 4, 1102–1115. [Google Scholar] [CrossRef] [PubMed]
- Moriguchi, K.; Yamamoto, S.; Tanaka, K.; Kurata, N.; Suzuki, K. Trans-kingdom horizontal DNA transfer from bacteria to yeast is highly plastic due to natural polymorphisms in auxiliary nonessential recipient genes. PLoS ONE 2013, 8, e74590. [Google Scholar] [CrossRef]
- Milner, D.S.; Attah, V.; Cook, E.; Maguire, F.; Savory, F.R.; Morrison, M.; Muller, C.A.; Foster, P.G.; Talbot, N.J.; Leonard, G.; et al. Environment-dependent fitness gains can be driven by horizontal gene transfer of transporter-encoding genes. Proc. Natl. Acad. Sci. USA 2019, 116, 5613–5622. [Google Scholar] [CrossRef]
- Shi, S.; Ji, H.; Siewers, V.; Nielsen, J. Improved production of fatty acids by Saccharomyces cerevisiae through screening a cDNA library from the oleaginous yeast Yarrowia lipolytica. FEMS Yeast Res. 2016, 16, fov108. [Google Scholar] [CrossRef] [PubMed]
- Wang, Z.; Qi, Q.; Lin, Y.; Guo, Y.; Liu, Y.; Wang, Q. QTL analysis reveals genomic variants linked to high-temperature fermentation performance in the industrial yeast. Biotechnol. Biofuels 2019, 12, 59. [Google Scholar] [CrossRef] [PubMed]
- Yang, Y.; Foulquie-Moreno, M.R.; Clement, L.; Erdei, E.; Tanghe, A.; Schaerlaekens, K.; Dumortier, F.; Thevelein, J.M. QTL analysis of high thermotolerance with superior and downgraded parental yeast strains reveals new minor QTLs and converges on novel causative alleles involved in RNA processing. PLoS Genet. 2013, 9, e1003693. [Google Scholar] [CrossRef]
- Narazaki, Y.; Nomura, Y.; Morita, K.; Shimizu, H.; Matsuda, F. Expression of Saccharomyces cerevisiae cDNAs to enhance the growth of non-ethanol-producing S. cerevisiae strains lacking pyruvate decarboxylases. J. Biosci. Bioeng. 2018, 126, 317–321. [Google Scholar] [CrossRef]
- Steensels, J.; Snoek, T.; Meersman, E.; Picca Nicolino, M.; Voordeckers, K.; Verstrepen, K.J. Improving industrial yeast strains: Exploiting natural and artificial diversity. FEMS Microbiol. Rev. 2014, 38, 947–995. [Google Scholar] [CrossRef]
- Riles, L.; Fay, J.C. Genetic basis of variation in heat and ethanol tolerance in Saccharomyces cerevisiae. G3 2019, 9, 179–188. [Google Scholar] [CrossRef] [PubMed]
- Caspeta, L.; Nielsen, J. Thermotolerant yeast strains adapted by laboratory evolution show trade-off at ancestral temperatures and preadaptation to other stresses. MBio 2015, 6, e00431. [Google Scholar] [CrossRef] [PubMed]
- Kitichantaropas, Y.; Boonchird, C.; Sugiyama, M.; Kaneko, Y.; Harashima, S.; Auesukaree, C. Cellular mechanisms contributing to multiple stress tolerance in Saccharomyces cerevisiae strains with potential use in high-temperature ethanol fermentation. AMB Express 2016, 6, 107. [Google Scholar] [CrossRef]
- Ishchuk, O.P.; Voronovsky, A.Y.; Abbas, C.A.; Sibirny, A.A. Construction of Hansenula polymorpha strains with improved thermotolerance. Biotechnol. Bioeng. 2009, 104, 911–919. [Google Scholar] [CrossRef] [PubMed]
- Riley, R.; Haridas, S.; Wolfe, K.H.; Lopes, M.R.; Hittinger, C.T.; Goker, M.; Salamov, A.A.; Wisecaver, J.H.; Long, T.M.; Calvey, C.H.; et al. Comparative genomics of biotechnologically important yeasts. Proc. Natl. Acad. Sci. USA 2016, 113, 9882–9887. [Google Scholar] [CrossRef]
- Ishii, J.; Izawa, K.; Matsumura, S.; Wakamura, K.; Tanino, T.; Tanaka, T.; Ogino, C.; Fukuda, H.; Kondo, A. A simple and immediate method for simultaneously evaluating expression level and plasmid maintenance in yeast. J. Biochem. 2009, 145, 701–708. [Google Scholar] [CrossRef] [PubMed]
- Ishii, J.; Morita, K.; Ida, K.; Kato, H.; Kinoshita, S.; Hataya, S.; Shimizu, H.; Kondo, A.; Matsuda, F. A pyruvate carbon flux tugging strategy for increasing 2,3-butanediol production and reducing ethanol subgeneration in the yeast Saccharomyces cerevisiae. Biotechnol. Biofuels 2018, 11, 180. [Google Scholar] [CrossRef]
- Wang, J.; Vasaikar, S.; Shi, Z.; Greer, M.; Zhang, B. WebGestalt 2017: A more comprehensive, powerful, flexible and interactive gene set enrichment analysis toolkit. Nucleic Acids Res. 2017, 45, W130–W137. [Google Scholar] [CrossRef]
- Verghese, J.; Abrams, J.; Wang, Y.; Morano, K.A. Biology of the heat shock response and protein chaperones: Budding yeast (Saccharomyces cerevisiae) as a model system. Microbiol. Mol. Biol. Rev. 2012, 76, 115–158. [Google Scholar] [CrossRef] [PubMed]
- Zyrina, A.N.; Smirnova, E.A.; Markova, O.V.; Severin, F.F.; Knorre, D.A. Mitochondrial superoxide dismutase and Yap1p act as a signaling module contributing to ethanol tolerance of the yeast Saccharomyces cerevisiae. Appl. Environ. Microbiol. 2017, 83, e02759-16. [Google Scholar] [CrossRef]
- Uesugi, S.; Watanabe, D.; Kitajima, M.; Watanabe, R.; Kawamura, Y.; Ohnishi, M.; Takagi, H.; Kimura, K. Calcineurin inhibitors suppress the high-temperature stress sensitivity of the yeast ubiquitin ligase Rsp5 mutant: A new method of screening for calcineurin inhibitors. FEMS Yeast Res. 2014, 14, 567–574. [Google Scholar] [CrossRef] [PubMed][Green Version]
- Nishimura, A.; Kawahara, N.; Takagi, H. The flavoprotein Tah18-dependent NO synthesis confers high-temperature stress tolerance on yeast cells. Biochem. Biophys. Res. Commun. 2013, 430, 137–143. [Google Scholar] [CrossRef] [PubMed]
- Coote, P.J.; Jones, M.V.; Seymour, I.J.; Rowe, D.L.; Ferdinando, D.P.; McArthur, A.J.; Cole, M.B. Activity of the plasma membrane H+-ATPase is a key physiological determinant of thermotolerance in Saccharomyces cerevisiae. Microbiology 1994, 140 (Pt 8), 1881–1890. [Google Scholar] [CrossRef]
- Gibney, P.A.; Lu, C.; Caudy, A.A.; Hess, D.C.; Botstein, D. Yeast metabolic and signaling genes are required for heat-shock survival and have little overlap with the heat-induced genes. Proc. Natl. Acad. Sci. USA 2013, 110, E4393–E4402. [Google Scholar] [CrossRef] [PubMed]
- Shima, J.; Hino, A.; Yamada-Iyo, C.; Suzuki, Y.; Nakajima, R.; Watanabe, H.; Mori, K.; Takano, H. Stress tolerance in doughs of Saccharomyces cerevisiae trehalase mutants derived from commercial Baker’s yeast. Appl. Environ. Microbiol. 1999, 65, 2841–2846. [Google Scholar] [CrossRef] [PubMed]

| Strain Name | Genotype | Source |
|---|---|---|
| Ogataea polymorpha BY4329 | Leu1-1 | Obtained from NBRP Yeast |
| Saccharomyces cerevisiae YPH499 | MATa, ura3-52 lys2-801_amber ade2-101_ochre trp1-Δ63 his3-Δ200 leu2-Δ1 | Thermo Scientific |
| TT01 | YPH499 (pGK416_BY4329 cDNA library) | This study |
| TT02 | YPH499 (pGK413_BY4329 cDNA library) | This study |
| TT03 | YPH499 (pGK414_BY4329 cDNA library) | This study |
| TT01c | YPH499 (pGK416) | This study |
| TT02c | YPH499 (pGK413) | This study |
| TT03c | YPH499 (pGK414) | This study |
| Escherichiacoli DH5α | deoR endA1 gyrA96 hsdR17(rk-mk+) recA1 relA1 supE44 thi-1Δ(lacZYA-argFV169) φ80lacZΔM15 F- | |
| Escherichiacoli HST08 | F,endA1, supE44, thi-1, recA1, relA1, gyrA96, phoA, Φ80d lacZΔM15, Δ(lacZYA-argF) U169, Δ(mrr-hsdRMS-mcrBC), ΔmcrA,λ– | |
| Plasmids | ||
| pGK413 | Yeast expression vector containing PGK1 promoter, origin, ARS4/CEN6 HIS3 marker, no expression (control plasmid) | [18] |
| pGK414 | Yeast expression vector containing PGK1 promoter, origin, ARS4/CEN6 TRP1 marker, no expression (control plasmid) | [18] |
| pGK416 | Yeast expression vector containing PGK1 promoter, origin, ARS4/CEN6 URA3 marker, no expression (control plasmid) | [18] |
| Colony ID | Gene ID of O. polymorpha (2) | S. cerevisiae Ortholog (3) | Functional Annotation of S. cerevisiae Ortholog |
|---|---|---|---|
| TT01-1 | OGAPODRAFT_7331 | CAF20 | cap-associated protein CAF20 |
| TT01-2 | OGAPODRAFT_52470 | QCR8 | ubiquinol-cytochrome c reductase subunit 8 |
| TT01-3 | OGAPODRAFT_16764 | ALD4 | aldehyde dehydrogenase |
| TT01-4 | HPODL_02546 | RPL16A | 60S ribosomal protein L16-B |
| TT01-5 | HPODL_00806 | GUP1 | acyltransferase |
| TT01-6 | OGAPODRAFT_17522 | THO1 | SAP domain-containing ribonucleoprotein |
| TT01-7 | OGAPODRAFT_12972 | HSP10 | chaperonin GroES |
| TT01-8 | OGAPODRAFT_52470 | QCR8 | ubiquinol-cytochrome c reductase subunit 8 |
| TT01-9 | HPODL_02610 | CYT1 | cytochrome c1, heme protein, mitochondrial |
| TT01-10 | HPODL_04437 | FRK1 | serine/threonine protein kinase |
| TT01-11 | OGAPODRAFT_15309 | PAF1 | RNA polymerase II-associated factor 1 |
| TT03-1 | HPODL_02637 | GRS1 | glycine--tRNA ligase 1, mitochondrial |
| TT03-2 | HPODL_00026 | NAP1 | histone chaperone NAP1 |
| TT03-3 | HPODL_05027 | NAB2 | mRNA-binding protein NAB2 |
| TT03-4 | HPODL_03235 | ERV25 | p24 family protein delta-1 |
| TT03-5 | HPODL_05028 | RPS2 | ribosomal 40S subunit protein S2 |
| TT03-6 | OGAPODRAFT_25583 | RIB3 | 3,4-dihydroxy-2-butanone-4-phosphate synthase RIB3 |
| TT03-7 | HPODL_03162 | ACB1 | long-chain fatty acid transporter ACB1 |
| TT03-8 | HPODL_01585 | RAD4 | DNA repair protein RAD4 |
| TT03-9 | HPODL_00194 | MRP7 | mitochondrial 54S ribosomal protein YmL2 |
| TT03-10 | HPODL_02367 | RPS31 | ubiquitin-ribosomal 40S subunit protein S31 fusion protein |
| TT03-11 | OGAPODRAFT_76806 | CYT2 | cytochrome c1 heme lyase CYT2 |
| TT03-12 | OGAPODRAFT_92206 | PSA1 | mannose-1-phosphate guanylyltransferase |
| TT03-13 | HPODL_01049 | GRX6 | glutathione-disulfide reductase GRX6 |
| TT03-14 | HPODL_00042 | RPL7A | ribosomal 60S subunit protein L7A |
| TT03-15 | HPODL_04105 | RPL42A | ribosomal 60S subunit protein L42A |
| TT03-16 | OGAPODRAFT_17069 | PTI1 | cleavage polyadenylation factor subunit PTI1 |
| TT03-17 | HPODL_01073 | ANB1 | translation elongation factor eIF-5A |
| TT03-18 | HPODL_02594 | MMF1 | isoleucine biosynthesis protein MMF1 |
| TT03-19 | OGAPODRAFT_102344 | PGK1 | 3-phosphoglycerate kinase |
| TT03-20 (4) | HPODL_02458 | SOD2 | superoxide dismutase SOD2 |
| TT03-21 (4) | HPODL_02693 | PFK26 | 6-phosphofructo-2-kinase |
| TT03-22 | HPODL_02169 | TAF9 | transcription initiation factor TFIID subunit 9 |
| TT03-23 (4) | HPODL_01966 | RAD6 | E2 ubiquitin-conjugating protein RAD6 |
| TT03-24 | HPODL_02705 | RPL1A | ribosomal 60S subunit protein L1A |
| TT03-25 (4) | HPODL_01497 | ASC1 | guanine nucleotide-binding protein subunit beta |
| TT03-26 | HPODL_01957 | MET5 | sulfite reductase (NADPH) subunit beta |
| TT03-27 | OGAPODRAFT_75779 | CEP3 | centromere DNA-binding protein complex CBF3 subunit B |
| TT03-28 | HPODL_03364 | RPL23B | ribosomal 60S subunit protein L23B |
| TT03-29 (4) | HPODL_00942 | RPP2B | ribosomal protein P2B |
| TT03-30 | HPODL_01497 | ASC1 | guanine nucleotide-binding protein subunit beta |
| TT03-31 | HPODL_02465 | SER2 | phosphoserine phosphatase |
| TT03-32 | OGAPODRAFT_74529 | STE5 | pheromone-responsive MAPK scaffold protein |
| TT03-33 (4) | HPODL_03495 | ACC1 | acetyl-CoA carboxylase |
| TT03-34 | OGAPODRAFT_16247 | DEG1 | pseudouridine synthase DEG1 |
| TT03-35 | OGAPODRAFT_76195 | STM1 | Uncharacterized protein |
| TT03-36 | OGAPODRAFT_17428 | SLM1 | phosphatidylinositol 4,5-bisphosphate-binding protein |
| TT03-37 | OGAPODRAFT_15585 | RPS26A | ribosomal 40S subunit protein S26A |
| TT03-38 | HPODL_03366 | SNF3 | high-affinity glucose transporter SNF3 |
| TT03-39 | HPODL_03527 | IDP1 | isocitrate dehydrogenase (NADP(+)) |
| TT03-40 (4) | OGAPODRAFT_7594 | SOM1 | mitochondrial export protein Som1 |
| TT03-41 | HPODL_02149 | ETR1 | trans-2-enoyl-CoA reductase |
| TT03-42 | HPODL_04585 | MYO5 | myosin-5 |
| TT03-43 | HPODL_01873 | SBA1 | hsp90 cochaperone SBA1 |
| TT03-44 (4) | HPODL_01380 | PRY2 | sterol-binding protein |
| TT03-45 | HPODL_01021 | RPS27B | ribosomal 40S subunit protein S27B |
| TT03-46 | HPODL_02251 | n.d. | n.d. |
| TT03-47 | HPODL_04413 | n.d. | n.d. |
| TT03-48 (4) | OGAPODRAFT_16908 | n.d. | n.d. |
| TT03-49 (4) | OGAPODRAFT_15905 | n.d. | n.d. |
| GO Term | False Discovery Rate (FDR) | Number of Matches | |
|---|---|---|---|
| structural constituent of ribosome | GO:0003735 | 0.000014579 | 11 |
| translation | GO:0006412 | 0.00028796 | 9 |
| ribosome | GO:0005840 | 0.047143 | 6 |
Publisher’s Note: MDPI stays neutral with regard to jurisdictional claims in published maps and institutional affiliations. |
© 2021 by the authors. Licensee MDPI, Basel, Switzerland. This article is an open access article distributed under the terms and conditions of the Creative Commons Attribution (CC BY) license (https://creativecommons.org/licenses/by/4.0/).
Share and Cite
Seike, T.; Narazaki, Y.; Kaneko, Y.; Shimizu, H.; Matsuda, F. Random Transfer of Ogataea polymorpha Genes into Saccharomyces cerevisiae Reveals a Complex Background of Heat Tolerance. J. Fungi 2021, 7, 302. https://doi.org/10.3390/jof7040302
Seike T, Narazaki Y, Kaneko Y, Shimizu H, Matsuda F. Random Transfer of Ogataea polymorpha Genes into Saccharomyces cerevisiae Reveals a Complex Background of Heat Tolerance. Journal of Fungi. 2021; 7(4):302. https://doi.org/10.3390/jof7040302
Chicago/Turabian StyleSeike, Taisuke, Yuki Narazaki, Yoshinobu Kaneko, Hiroshi Shimizu, and Fumio Matsuda. 2021. "Random Transfer of Ogataea polymorpha Genes into Saccharomyces cerevisiae Reveals a Complex Background of Heat Tolerance" Journal of Fungi 7, no. 4: 302. https://doi.org/10.3390/jof7040302
APA StyleSeike, T., Narazaki, Y., Kaneko, Y., Shimizu, H., & Matsuda, F. (2021). Random Transfer of Ogataea polymorpha Genes into Saccharomyces cerevisiae Reveals a Complex Background of Heat Tolerance. Journal of Fungi, 7(4), 302. https://doi.org/10.3390/jof7040302

